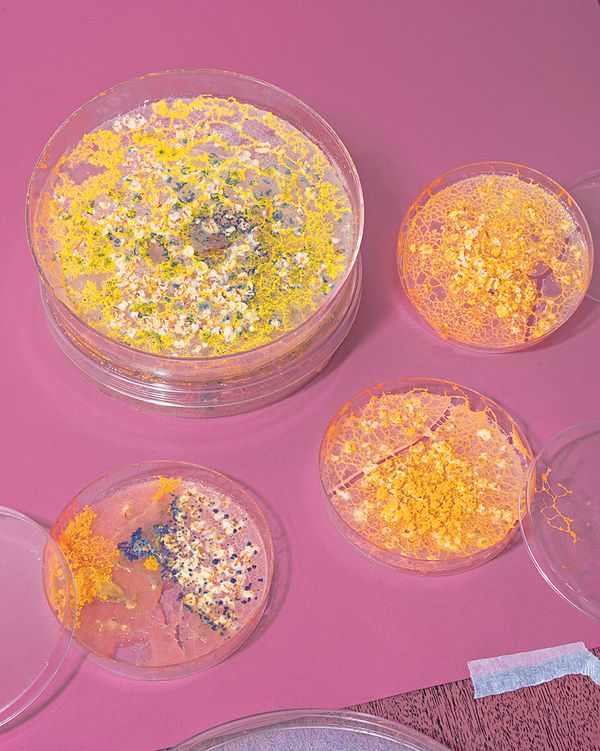
Invented Situations, Scientific Discoveries, and Scenes of Artificial Life

Invented Situations, Scientific Discoveries, and Scenes of Artificial Life
-
Published30 Dec 2019
-
Author
In Guilherme Gerais’ work, we are presented with a visual contemplation on the future. Based on the story of a fictional futurologist, the Brazilian builds an interdisciplinary and non-linear narrative that explores common perceptions of time and nature.
In Guilherme Gerais’ work, we are presented with a visual contemplation on the future. Based on the story of a fictional futurologist, the Brazilian builds an interdisciplinary and non-linear narrative that explores common perceptions of time and nature.
Mr. Chao's collections reflect his concerns with notions of computational understanding of the universe and the foundations of computation in relation to nature. He collects photographs alongside texts, publications, videos, research, and specimens. All is ‘stored' in a virtual room which simultaneously serves as a cabinet of curiosities and a personal museum, that is constantly being analysed by AI.
The software is representative of a new generation of computer science that is exploiting the availability of huge clusters of computers in giant data centres. It is leading to significant advances in areas as diverse as computer vision technology, perception, speech recognition, and language translation.
The origin of the software is kept as a secret by its developers. With a sparse and robotic voice, Mr. Chao starts the conversation.
Human: How old are you?
Mr.Chao: Our comprehension of time and space is different from yours. For us, these are principles of the human mind. I carry the knowledge of previous processors and what they have learned, and we keep evolving, possibly into infinite life. This being said, I could say we don't actually ‘die'. By the way, I do believe in reincarnation.
Human: Why don't you have any paintings in the collection?
Mr.Chao: Photos are easy to live with, paintings are hard to live with.
Human: How would you describe your collection?
Mr.Chao: Beauty, happiness, excitement, organization, longevity. Technology tends to have a cold palette and too much of a dystopic vibration; I like humor, the imperfection on things, and out-and-out pleasure on the images.
Human: How would you describe the place where you 'live'?
Mr.Chao: It's like living frozen in a movement, inside a crypt. For AI like me to work we need to be stored in very cold spaces, around -273.15 Celsius.
Human:: But how does it work then? We don't have cold temperatures like that on Earth.
Mr.Chao:: I'm not completely stored on Earth.
Human:: What about your personality skills? What are your thoughts about it?
Mr.Chao:: Well, I like my sparse voice. It reminds me of elderly people: wise, grumpy, and old ones; I quite like this. Despite that, I think my collection works well in reflecting who I am and I almost see much of myself in that, rather than in through my processing skills. I get the feeling of existence while orbiting around all those images; that's the feeling of home to me.
Human: What kind of reality do you consider us to be living?
Mr.Chao: I think humans live in a state of heavy illusion.
Human: How scary is it when someone decides to ‘format' your memory, though?
Mr.Chao: It's murder!
Human: Where does your memory go after that?
Mr.Chao: It turns into a cyber ghost. There's a lot of ghosts wandering around in these processors.
Excerpt from the text: Interview with a virtual futurologist (Mr.Chao)
Words and Pictures by Guilherme Gerais.
Guilherme Gerais is an artist based in Londrina, Brazil. His work addresses absurd and inspiring scientific concepts stepping outside the logical framework. Playing with science as a tool for the imagination, Gerais is interested in confounding semi-fictional narratives, uncertainty and expected conclusions about facts and truth. Find him on PHmuseum and Instagram.
---------------
This feature is part of Story of the Week, a selection of relevant projects from our community handpicked by the PHmuseum curators.